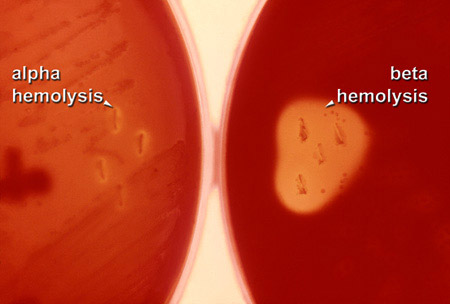
809896894586949.jpg
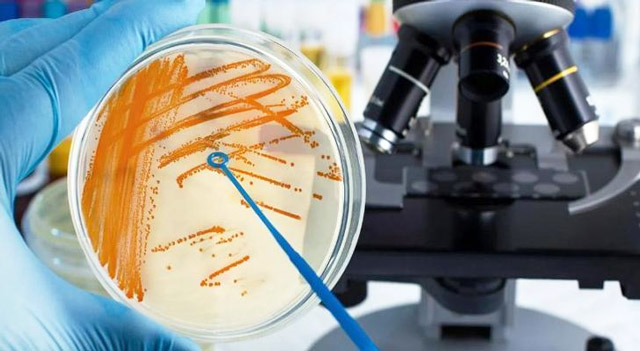
458604985694859499.jpg

Гемолитический стрептококк (streptococcus haemolyticus) возбудитель большой группы острых и хронических инфекционных заболеваний, поражающих преимущественно органы респираторного и урогенитального трактов, кожный покров, соединительную ткань, кровь. В основе всех патологий, вызываемых гемолитическим стрептококком, лежат схожие этиопатогенетические процессы, особенности эпидемиологии и патоморфологические изменения. Стрептококковая инфекция имеет разнообразные клинические проявления и требует проведения полноценного противомикробного лечения.
Все стрептококки, обладающие гемолитической активностью, подразделяются на две большие группы по способу разрушения эритроцитов — с альфа- и бета-гемолизом.
- Альфа-гемолитические образование на средах с кровью зеленоватой зоны вокруг колоний, обусловленной частичным гемолизом. Пневмококк относится к данной группе и вызывает воспаление легких и ЛОР-органов.
- Бета-гемолитические прозрачная зона вокруг колоний, связанная с полным разрушением клеток крови. Бактерии этой группы образуют несколько подгрупп, отличающихся типом строения клеточной стенки. Самыми значимыми в медицинском отношении являются стрептококки группы А. Они обитают в носоглотке человека и вызывают местное воспаление. Больные с поражением горла очень опасны в эпидотношении: они выделяют микробы при кашле, разговоре, чихании. Основной представитель данного вида гноеродный стрептококк. К группе В относится Streptococcus agalactiae, поражающий урогенитальный тракт. Все остальные микроорганизмы этого вида являются менее распространенными и опасными для человека.
Гемолитический стрептококк обитает в организме здорового человека в незначительном количестве. Он локализуется в органах дыхания и мочевыделительной системы и не приносит вреда здоровью. Под воздействием негативных эндогенных и экзогенных факторов, снижающих иммунитет и общую резистентность, число бактерий резко увеличивается, а их патогенные свойства усиливаются. В макроорганизме развивается воспаление, локализация которого определяется местом расположения очага поражения.
- Streptococcus pyogenes самый опасный микроб из рода стрептококков. Он легко внедряется и быстро колонизирует слизистую оболочку, вызывая развитие местного воспаления. После размножения микробные клетки распространяются по всему организму и становятся причиной заболеваний крови, органов дыхания и кожи.
- Streptococcus pneumoniae обладает тропизмом к легочной ткани. Он вызывает воспаление легких, а в более редких случаях ЛОР-органов: глотки, миндалин, носа, пазух, уха. В тяжелых случаях возможно развитие бактериемии и прочих смертельно опасных гнойных осложнений менингита, артрита, остеомиелита, эндокардита.
- Streptococcus agalactiae естественный обитатель кишечника, глотки, уретры и влагалища. При иммунной дисфункции он вызывает заболевания в местах своей локализации: во влагалище неспецифическое воспаление, в кишечнике дисбиоз, в носу ринит, у мужчин острый уретрит или простатит.
Гемолитический стрептококк особо опасен для:
- Беременных женщин,
- Детей, рожденных раньше срока,
- Пожилых людей,
- Больных с иммунодефицитом,
- Лиц, перенесших острые респираторные вирусные инфекции,
- Алкоголиков,
- Пациентов с хроническими патологиями в анамнезе.
Диагноз заболеваний, вызванных Streptococcus haemolyticus, ставят после проведения всестороннего обследования больного. Важное значение в диагностике имеет бактериологический анализ биоматериала. Инструментально-лабораторные методы позволяют определить степень тяжести патологии, уровень поражения и общее состояние макроорганизма. Специалисты проводят антибактериальную, десенсибилизирующую и противовоспалительную терапию, а также назначают препараты, устраняющие основные клинические проявления инфекции.
Этиология и патогенез
Гемолитический стрептококк шарообразные или эллипсоидные микроорганизмы, которые благодаря своей форме называются кокками. Они имеют капсулу и группоспецифический полисахарид. Стрептококки факультативные анаэробы, не образующие спор и не обладающие двигательной активностью.
-
Тинктриальные свойства: окраска по Грамму положительная, расположение в мазке попарное или в виде коротких цепочек.
- Культуральные свойства. Для роста и размножения стрептококков необходимы специальные питательные среды с компонентами крови. Эти источники энергии необходимы бактериям для полноценного развития. В бульоне с глюкозой культура дает равномерную муть с осадком, а на агаре с кровью образует мелкие, полупрозрачные колонии с зоной гемолиза. Бактерии не обладают каталазной и оксидазной активностью, но расщепляют многие углеводы.
- Патогенность. Бактерии выделяют ферменты и токсины, обуславливающие их способность вызывать воспаление. Благодаря токсину, стрептолизину, лейкоцидину, некротоксину, гиалуронидазе и стрептокиназе микробы разрушают клетки крови, подавляют иммунитет, вызывают некроз тканей, нарушают работу всего организма. Ферменты обеспечивают фиксацию стрептококка на эпителии, его внедрение внутрь клетки, выход в системный кровоток и распространение по всему организму. Основное патогенное действие гемолитического стрептококка деструкция красных кровяных телец. Бактерии выделяют токсины, негативно воздействующие практически на все органы.
- Резистентность. Гемолитический стрептококк устойчив к гипертермии, заморозке, высушиванию и ультрафиолету. Он долгое время остается жизнеспособным в окружающей среде, постепенно теряя свои болезнетворные качества. Микроб погибает под воздействием дезинфицирующих, антисептических и противомикробных средств.
После внедрения бактерий в организм, они колонизируют слизистую оболочку, проникают в клетки эпителия, размножаются и разрушают их. В месте первичной локализации возбудителя развивается очаг воспаления, проявляющийся болью, отеком и гиперемией. Когда количество микробов превышает допустимый уровень, они прорываются в кровь, возникает бактериемия. У больного постепенно нарастает интоксикационный синдром, проявляющийся недомоганием, лихорадкой, ознобом. Гематогенным путем стрептококки разносятся к лимфоузлам и внутренним органам, вызывая их поражение. Если организм воспринимает оболочку бактерий как аллерген, развивается асептическое воспаление, повреждающее почки, миокард, суставы. Осложнениями интоксикационного синдрома при стрептококковой инфекции являются: дегидратация, поражение ЦНС, помрачение сознания.
Врачи отмечают, что гемолитический стрептококк представляет собой группу бактерий, разделяемую на несколько видов, наиболее известными из которых являются Streptococcus pyogenes и Streptococcus agalactiae. Эти микроорганизмы могут вызывать различные заболевания, от легких инфекций до серьезных осложнений, таких как ревматизм и гломерулонефрит. Диагностика основана на клинических проявлениях и лабораторных тестах, включая посевы и серологические исследования. Лечение, как правило, включает антибиотики, причем выбор препарата зависит от чувствительности бактерий. Врачи подчеркивают важность своевременной диагностики и адекватного лечения, чтобы предотвратить возможные осложнения и обеспечить быстрое выздоровление пациента.
Эпидемиология
Гемолитический стрептококк распространен повсеместно. Развитие патологии он вызывает двумя способами: путем проникновения в организм человека извне или в результате активного размножения в местах своего постоянного обитания в носоглотке, кишечнике, влагалище, уретре.
Факторы, провоцирующие активацию и размножение стрептококка:
- Падение иммунной защиты,
- Хронические патологии в стадии декомпенсации,
- Дисфункция эндокринной системы,
- Частые и тяжелые ОРВИ,
- Дисбактериоз кишечника,
- Стрессовые воздействия нервные срывы, эмоциональные всплески,
- Общая или местная гипотермия,
- Последствия операций и инвазивных манипуляций,
- Самостоятельное лечение антибиотиками,
- Химиотерапия, гормонотерапия,
- Тяжелый физический труд,
- Загрязнение окружающей среды.
Возможно заражение здоровых людей от больных и бессимптомных носителей. Пути распространения инфекции разнообразные: контактно-бытовой, аэрогенный, алиментарный, половой, вертикальный. Самыми опасными в эпидотношении являются лица с заболеваниями горла. Они заражают окружающих людей, когда кашляют, чихают или близко общаются. Бактерии вместе с капельками слюны, мокроты или отделяемого зева попадают во внешнюю среду.
Пути передачи
Бета-гемолитический стрептококк группы А (Streptococcus pyogenes) передается разными способами. Самое распространенное заражение происходит извне от больного носителя. Пути передачи инфекции:
- Воздушно-капельный. Распространение инфекции происходит через кашель, разговор, чихание. Бактерии сначала распространяются по воздуху, а затем заглатываются здоровым человеком.
- Контактно-бытовой. Заражение через личные вещи больного или грязные руки.
- Алиментарный. Инфицирование происходит через пищевые продукты, которые не прошли тепловую обработку.
- Половой. Передача инфекции производится во время незащищенного полового акта.
- Внутриутробный. Заражение происходит от беременной матери к ребенку.
Существует еще артифициальный механизм передачи возбудителя. Искусственное инфицирование происходит в лечебных учреждениях во время инвазивных процедур (в стоматологической практике, при удалении миндалин или аденоидов). Streptococcus pyogenes, как и другие виды стрептококков, проявляется быстро. Длительность инкубационного периода в среднем составляет от 1 до 5 суток.
Стрептококковая инфекция: где живет? Детский доктор
Гемолитический стрептококк — это группа бактерий, вызывающих различные инфекции у человека. Существует несколько видов, наиболее известные из которых — Streptococcus pyogenes и Streptococcus agalactiae. Эти микроорганизмы классифицируются по способности вызывать гемолиз, что позволяет выделить альфа-, бета- и гамма-гемолитические стрептококки. Бета-гемолитические стрептококки, в частности, могут вызывать такие заболевания, как ангина, скарлатина и инфекционные осложнения.
Диагностика инфекций, вызванных гемолитическими стрептококками, включает микробиологические исследования, такие как посев на питательные среды и ПЦР. Лечение обычно основано на назначении антибиотиков, таких как пенициллин, который эффективно справляется с большинством стрептококковых инфекций. Однако важно учитывать индивидуальные особенности пациента и возможные аллергические реакции. Профилактика включает в себя соблюдение гигиенических норм и своевременное обращение к врачу при первых симптомах заболевания.
Бета гемолитический стрептококк в зеве
Стрептококковая ангина, вызванная появлением микроба в зеве, проявляется болями в горле, высокой температурой, гнойным налетом на миндалинах и т.д. Налет всегда гнойный, окрашенный в бело-желтый цвет. Кроме того, у человека присутствуют симптомы общей интоксикации (вялость, головная боль, озноб, слабость и т.д.).
При осмотре зева выявляются покраснение нёбных дужек, язычка и задней стенки глотки, миндалины увеличены в размере, отечны и разрыхлены. Боль в горле может иметь различную степень выраженности, в зависимости от тяжести течения ангины.
Также для стрептококковой ангины характерно увеличение и воспаление лимфоузлов и лимфососудов. Обычно данные симптомы бета-гемолитического стрептококка сохраняются на протяжении 5 7 дней, а затем проходят, и наступает выздоровление.
Однако такие же точно симптомы присущи и ангине, вызываемой другими бактериями. Поэтому симптомы бета-гемолитического стрептококка в зеве не являются строго специфичными, и не позволяют по их характеру верифицировать микроб-возбудитель.
В ряде случаев бета-гемолитический стрептококк, находящийся в зеве, вызывает скарлатину, которая характеризуется симптомами ангины и сыпи на теле. В таком случае симптомами, кроме боли в горле, температуры и фарингита, будет еще и мелкая красная сыпь на теле и малиновый язык. Такую сыпь и малиновый язык можно отнести к специфическим симптомам бета-гемолитического стрептококка в зеве, которые однозначно свидетельствуют о том, что возбудителем инфекции является именно этот микроб.
У детей до 3-х лет бета-гемолитический стрептококк в зеве может проявляться следующими симптомами:
- Ринит;
- Заложенный нос;
- Несильное повышение температуры.
Ангина до 3-х летнего возраста практически никогда не развивается вследствие особенностей местного
То есть заболеание протекает или бессимптомно, или в виде обычной ангины, признаки которой не являются специфическими.
Симптоматика
Бета-гемолитический стрептококк группы А самый частый возбудитель инфекционных заболеваний горла, протекающих в форме фарингита и тонзиллита.
Больные с острым воспалением глотки жалуются на неприятные ощущения при глотании, сухость, першение в горле и общий дискомфорт. У них возникает слабость, цефалгия, субфебрилитет, изменяется голос. Увеличиваются и болят затылочные и подчелюстные лимфоузлы, появляется заложенность ушей.
Хроническая форма фарингита протекает более спокойно. У больных отсутствуют признаки интоксикации, их состояние остается удовлетворительным. Основные симптомы инфекции першение и сухость в горле, наличие кома, вызывающего частые покашливания и отхаркивания. Со временем возникает сухой, мучительный кашель. Слизь на задней стенке глотки требует постоянного сглатывания. Это раздражает больных, нарушает их сон и аппетит.
Острое воспаление небных миндалин или тонзиллит начинается внезапно. У больных увеличиваются региональные лимфоузлы, возникает сильная боль в горле. Патология всегда сопровождается выраженной интоксикацией. Температура тела достигает фебрильных значений, появляется сотрясающий озноб, миалгия и артралгия, общая слабость, цефалгия, диспепсия. Боль в горле нарастает и становится нестерпимой. Больные не могут нормально есть и говорить. Даже процесс проглатывания слюны вызывает резкую боль. Слизистая оболочка глотки краснеет, миндалины отекают и покрываются гнойным налетом.
Если острое воспаление вовремя не лечить, произойдет хронизация процесса. Такая форма часто протекает без видимых симптомов и диагностируется намного сложнее. Заболевание проявляется периодически возникающей болью в горле, которая усиливается во время еды, болезненностью подчелюстных лимфоузлов, сухостью во рту, покашливанием по утрам с выделением незначительного количества гнойной мокроты. Обострения болезни возникают всякий раз при снижении иммунитета. При этом повышается температура, и разворачивается полная картина острого воспаления.
Диагностические мероприятия
Диагностика заболеваний, вызванных Streptococcus haemolyticus, начинается с опроса и осмотра больного, сбора анамнеза жизни и болезни, физикального обследования. Основным методом определения этиологии инфекционной патологии, является бактериологический. В условиях микробиологической лаборатории исследуют биологический материал, взятый от больного мокроту, слизь из зева и носа, кровь, ликвор, мочу.
Материал для исследования засевают на селективные питательные среды с кровью кровяной или шоколадный агар. Для подращивания и обогащения культуры производят посев в сахарный бульон. Инкубацию проводят в термостате при 37С сутки. Затем учитывают результаты путем изучения выросших колоний. Обычно это мелкие сероватые или полупрозрачные колонии, окруженные прозрачной или зеленоватой зоной.
Микроскопия обязательный этап любого бактериологического исследования. Мазки окрашивают по Грамму и микроскопируют на максимальной увеличении в световом микроскопе. В поле зрения обнаруживают синие мелкие кокки шаровидные клетки, расположенные цепочками, иногда парами. В бульоне бактерии растут с образованием диффузного помутнения и осадка на дне пробирки. Дальнейшее исследование направлено на идентификацию выделенного микроорганизма до вида. Для этого ставят тесты с оптохином, бацитрацином, желчью, делают посев в молоко с метиленовой синькой. Клиницистам необходимо знать, к каким антибиотикам чувствителен микроб. По результатам антибиотикограммы они назначают лечение больным.
Серологическое и иммунологическое исследованияпроводят с кровью пациентов. С помощью различных модификаций реакции агглютинации и иммуноферментного анализа определяют наличие антител к стрептококку и количество иммуноглобулинов каждого вида.
ПЦР экспресс-метод, позволяющий поставить диагноз быстро и точно. В исследуемом образце крови или отделяемого носоглотки находят генетический материал Streptococcus haemolyticus.
Лечение у взрослых
Бета-гемолитический стрептококк необходимо лечить только в том случае, если он вызвал острое инфекционно-воспалительное заболевание (ангину, фарингит, скарлатину, ринит, синусит и т.д.).
Лечение стрептококка в этом случае проводится антибиотиками. В принципе стрептококковая ангина и без антибиотиков пройдет самостоятельно через неделю. Однако если не применять антибиотиков для лечения ангины, вызванной бета-гемолитическим стрептококком, то высок риск осложнений, таких, как ревматизм, миокардит, гломерулонефрит и т.д.
То есть, антибиотики в лечении стрептококковых ангин необходимы в качестве основного средства профилактики воспалительных инфекций других органов, куда микроб может быть занесен с током крови.
Лечение бета-гемолитического стрептококка при помощи антибиотиков необходимо для эрадикации микроба и предотвращения осложнений. Для терапии чаще всего применяют антибиотики из группы пенициллинов, макролидов или цефалоспоринов. При неэффективности пенициллинов и цефалоспоринов используют линкосамиды.
Для лечения бета-гемолитического стрептококка применяют следующие системные антибиотики:
- Бензилпенициллин вводится внутривенно до 6 раз в сутки;
- Феноксиметилпенициллин принимается внутрь по 375 мг (дети) или 750 мг (взрослые) по 2 раза в день;
- Амоксициллин (Флемоксин Солютаб) принимается внутрь по 375 мг (дети) или 750 мг (взрослые) по 2 раза в день;
- Аугментин (Амоксиклав) принимается внутрь по 375 мг (дети) или 750 мг (взрослые) по 2 раза в день;
- Азитромицин (Сумамед) взрослые принимают по 500 мг в первые сутки по 250 мг в последующие дни лечения. У детей дозировка рассчитывается исходя из соотношения 12 мг на 1 кг массы тела;
- Цефуроксим вводится внутривенно или внутримышечно по 30 мг на 1 кг массы тела в сутки по 2 раза в день. Кроме того может приниматься в таблетках по 250 500 мг по 2 раза в день;
- Цефтазидим (Фортум) вводится внутривенно или внутримышечно по 100 150 мг на 1 кг массы тела в сутки. Вся доза антибиотика вводится за одну инъекцию;
- Цефтриаксон вводится внутривенно или внутримышечно по 20 80 мг на 1 кг массы тела в сутки. Вся доза антибиотика вводится за одну инъекцию;
- Цефотаксим вводится внутривенно или внутримышечно по 50 100 мг на 1 кг массы тела в сутки. Вся доза антибиотика вводится за одну инъекцию. Данный препарат применяют при неэффективности ранее использовавшихся антибиотиков;
- Цефиксим (Cупракс) принимают по 400 мг 1 раз в день;
- Джозамицин принимают по 40 50 мг на 1 кг массы тела в сутки;
- Мидекамицин (Макропен) принимают по 40 50 мг на 1 кг массы тела в сутки;
- Кларитромицин принимают по 6 8 мг на 1 кг массы тела в сутки;
- Рокситромицин принимают по 6 8 мг на 1 кг массы тела в сутки;
- Спирамицин (Ровамицин) принимают по 100 ЕД на 1 кг массы тела по 2 раза в сутки;
- Эритромицин принимают по 50 мг на 1 кг массы тела в сутки.
Длительность лечения бета-гемолитического стрептококка составляет 7 10 дней. Если антибиотики применяются более короткими курсами, то это часто приводит к хронизации инфекции и последующим рецидивам.
Кроме того, в качестве вспомогательных средств для лечения бета-гемолитического стрептококка применяют местные средства, содержащие антибиотики или антисептики. Данные средства выпускаются в форме аэрозолей, таблеток и конфет для рассасывания. В настоящее время наиболее эффективными местными препаратами для лечения бета-гемолитического стрептококка являются следующие:
- Биопарокс спрей, содержащий антибиотик Фюзафюнжин. Применяется местно в виде впрыскиваний в горло и носовые ходы;
- Ингалипт спрей, содержащий сульфаниламидный препарат. Применяется местно в виде впрыскиваний в горло;
- Тонзилгон Н растительный иммуномодулирующий и противовоспалительный препарат, который принимается в форме капель или драже;
- Гексорал раствор для полоскания горла или спрей, содержащий антисептик. Применяется местно для впрыскивания или полоскания горла;
- Хлоргексидин содержится в таблетках для рассасывания (например, Гексорал, Анти-Ангин, Себидин, Фарингосепт и др.);
- Цетилпиридин содержится в таблетках для рассасывания (Септолете и т.д.);
- Дихлорбензоловый спирт содержится в спреях и таблетках для рассасывания (Стрепсилс, Ринза Лорсепт, Аджисепт, Астрасепт, Суприма-ЛОР, Терасил и т.д.);
- Йод содержится в растворах для полосканиях горла и спреях (Йодинол, Йокс, Вокадин, Повидонйод).
Народная медицина
Такую инфекцию можно лечить и в домашних условиях, дополняя назначенную медикаментозную терапию народными рецептами. Они помогут устранить неприятные симптомы патологии, снимут воспаление и повысят иммунитет:
- листья малины и шиповника;
- кора ивы и трава череды;
- прополис.
Осложнения
Осложнения встречаются редко, но все же имеют место, особенно у людей со слабой иммунной системой. Все их можно условно разделить на две группы ранние и поздние.
Ранние осложнения проявляются на 47 день от начала прогрессирования инфекции.
Поздние осложнения могут проявить себя через 24 недели после мнимого выздоровления пациента. Как правило, они напрямую связаны с несоблюдением терапии, отсутствием антибиотикотерапии. В эту группу относят:
Вылечить стрептококковые недуги горла можно только с подключением антибиотиков. Правильно назначенное лечение это залог скорого выздоровления пациента, а также исключение развития у него осложнений.
Важно сначала провести диагностику недуга. Обычно для этой цели используют БАК-посев. Из горла пациента берут мазок и высеивают его на питательную среду, чтобы выявить возбудителя. До момента получения результатов, пациенту назначаются антимикробные препараты широкого спектра действия.
Длительность антибиотикотерапии составляет от 7 о 10 дней. Если болезнь протекает в тяжёлой форме, то назначают не таблетированные формы указанных препаратов, а растворы и порошки для в/м введения. Предпочтение отдаётся антибиотикам из группы пенициллинов. В случае если у пациента есть аллергия на средства из данной группы, предпочтение отдаётся цефалоспоринам. При прогрессировании скарлатины к общему курсу терапии добавляют также макролиды.
Лечение стрептококковой инфекции также должно быть направлено на устранение основных симптомов патологии. С этой целью назначаются следующие препараты и процедуры:
- промывание горла и миндалин;
- употребление жидкости (в теплом виде);
- сосудосуживающие средства;
- жаропонижающие препараты;
- рассасывание антисептических таблеток.
Профилактика
Мероприятия, предупреждающие инфицирование гемолитическим стрептококком:
- Закаливающие процедуры контрастный душ, обливания холодной водой, ходьба босиком,
- Соблюдение санитарно-гигиенических норм и правил мытье рук перед едой, регулярное проветривание помещения, тщательная уборка комнаты,
- Полноценная физическая активность утренняя гимнастика, занятия любимым видом спорта, долгие пешие прогулки, плавание, подвижные танцы,
- Сбалансированный рацион с достаточным количеством витаминов и микроэлементов,
- Отказ от алкоголя и курения,
- Своевременное лечение синуситов, отита, ринофарингита, кариеса,
- Защита организма от сквозняков, ношение одежды по сезону,
- Использование маски в общественных местах во время эпидемий гриппа,
- Профилактический прием поливитаминных комплексов дважды в год.
Видео: cтрептококк, доктор Комаровский
Показания к исследованию:
- Наличие симптомов инфекционно-воспалительного заболевания, вызываемого Streptococcus pyogenes;
- Оценка эффективности антибактериальной терапии.
Интерпретация результатов:
Результат бактериологического исследования, в случае обнаружения бета-гемолитического стрептококка группы А (Streptococcus group A, S.pyogenes) предоставляется в количественном формате.
Интерпретация проводится врачом с учетом клинических проявлений.
Обращаем Ваше внимание на то, что интерпретация результатов исследований, установление диагноза, а также назначение лечения, в соответствии с Федеральным законом № 323-ФЗ Об основах охраны здоровья граждан в Российской Федерации от 21 ноября 2011 года, должны производиться врачом соответствующей специализации.
Вопрос-ответ
Что такое гемолитический стрептококк?
Гемолитический стрептококк (Streptococcus pyogenes) — вид грамположительных аэротолерантных бактерий рода Streptococcus. Такие бактерии являются внеклеточными и состоят из неподвижных и не образующих спор кокков (круглых клеток), которые имеют тенденцию связываться в цепочки.
Что такое гемолитические стрептококки?
Гемолитический стрептококк группы А также известен как возбудитель стрептококкового токсического шокового синдрома, который вызывает некроз тканей (отмирание тканей) и шок . *1Импетиго: общий термин для обозначения кожных заболеваний, основными симптомами которых являются пустулы (заполненные гноем волдыри на коже) и струпья.
Какие виды стрептококков бывают?
На данный момент времени принято выделять три основные группы стрептококков – альфа-, бета- и гамма-гемолитические. Такое деление основано на степени гемолиза эритроцитов в частности на кровяном агаре, который является питательной средой для роста этих бактерий.
Какой антибиотик убивает стрептококк?
Лечение стрептококковой инфекции проводится с использованием антибиотиков пенициллинового ряда: бензилпенициллин, ампициллин, бициллин-3 или бицилли-5 на третьи-четвертые сутки после начала лечения пенициллином. Устойчивость против пенициллиновых антибиотиков стрептококки приобрести не способны.
Советы
СОВЕТ №1
Перед тем как обращаться к врачу, обратите внимание на симптомы, такие как боль в горле, высокая температура и высыпания на коже. Это поможет врачу быстрее установить диагноз и назначить правильное лечение.
СОВЕТ №2
Не забывайте о важности лабораторной диагностики. Для точного определения типа стрептококка и его чувствительности к антибиотикам может потребоваться анализ мазка из горла или крови. Это поможет избежать неправильного лечения.
СОВЕТ №3
При лечении инфекций, вызванных гемолитическим стрептококком, строго следуйте рекомендациям врача и завершайте курс антибиотиков, даже если симптомы исчезли. Это поможет предотвратить рецидив и развитие устойчивости к препаратам.
СОВЕТ №4
Обратите внимание на профилактику. Соблюдение правил личной гигиены, регулярное мытье рук и избегание контакта с больными помогут снизить риск заражения гемолитическим стрептококком.